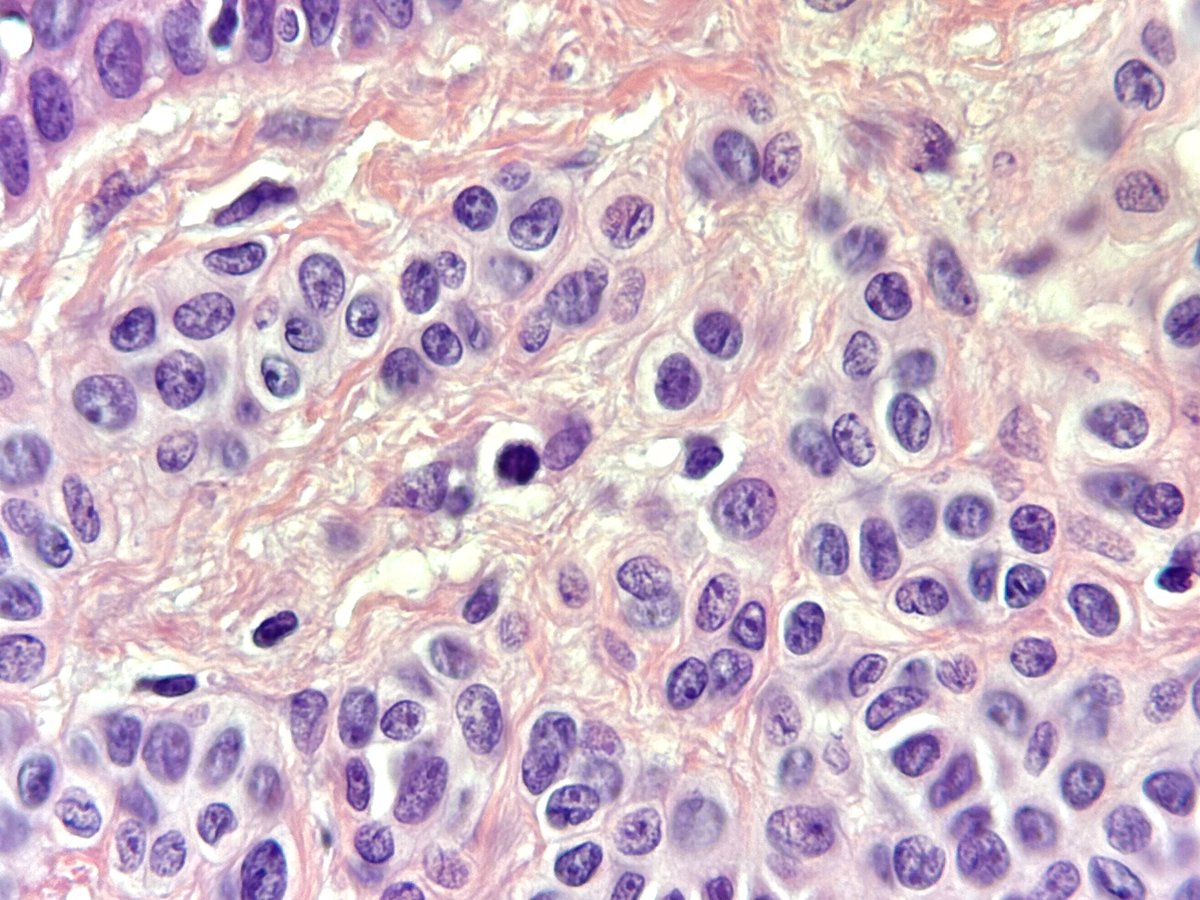
Francesco Fortarezza tweet media

#caseoftheday Tubular adenoma (a benign adnexal tumor) that, in this case, shows tubulo-cystic, papillary, eccrine, apocrine, and hydrocystoma-like features. In more than half of cases, the BRAF p.V600E mutation can be detected #pathology #dermpath #dermatology #PathX #MedX




English